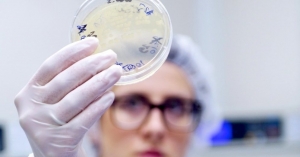

О проведении мероприятий по недопущению завоза лихорадки Зика на территорию Российской Федерации
Федеральная служба по надзору в сфере защиты прав потребителей и благополучия человека информирует о расширении ареала распространения лихорадки Зика на территориях Южноамериканского и Азиатско-тихоокеанского региона.
На 9.02.2016 случаи инфицирования зарегистрированы в 33 странах мира Североамериканского, Южноамериканского и Азиатско-тихоокеанского региона: Барбадос, Боливия, Бразилия, Кабо-Верде, Колумбия, Эквадор, Сальвадор, Фиджи, Французская Гвиана, Гваделупа, Гватемала. Гайана, Гаити, Гондурас, Мальдивы, Мартиника, Мексика, Новая Каледония, Панама, Парагвай, Пуэрто-Рико, Сен-Мартен, Самоа, Соломоновы острова, Суринам, Таиланд, Венесуэла, Никарагуа, Американская Самоа, Тонга, Коста-Рика, Сант-Мартин, о. Кюрасао.
Одной из наиболее неблагополучных стран является Бразилия.
Роспотребнадзором в целях обеспечения санитарно-эпидемиологического благополучия населения Российской Федерации организован и проводится комплекс мер, направленных на предупреждение завоза на территорию страны лихорадки Зика, в том числе по усилению санитарно-карантинного контроля при пересечении государственной границы. Организовано взаимодействие с заинтересованными федеральными органами исполнительной власти.
С начала 2016 года начат еженедельный мониторинг лиц, прибывающих из стран, неблагополучных по трансмиссивным лихорадкам (Южной и Центральной Америки и Карибского бассейна, Бразилии, Юго-Восточной Азии и Океании и Африки).
На 8.02.2016 в аэропортах и морских пунктах пропуска, принимающих рейсы из стран Южной и Центральной Америки и Карибского бассейна, Бразилии, Юго-Восточной Азии и Океании и Африки досмотрено более 400 транспортных средств и более 48,5 тысяч лиц на наличие признаков инфекционных заболеваний.
Подозрительных лиц с наличием симптомов лихорадки Зика не выявлено.
Ситуация остается на контроле Федеральной службы по надзору в сфере защиты прав потребителей и благополучия человека.
Другие новости по теме «События»